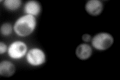
YMR120C
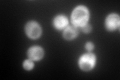
YMR120C

View description
Enzyme of 'de novo' purine biosynthesis containing both 5-aminoimidazole-4-carboxamide ribonucleotide transformylase and inosine monophosphate cyclohydrolase activities, isozyme of Ade16p; ade16 ade17 mutants require adenine and histidine
Localization:
Intensity:
Fold change:
Significance:
-
C’ GFP library in SD
cytosol469.55 -
N' NOP1pr-GFP in SD

cytosol179.056 -
N' TEF2pr-mCherry in SD

cytosol300.012 -
N' NATIVEpr-GFP in SD

cytosol436.338 -
N' TEF2pr-VC and Cyto-VN in SD

cytosol90.8018 -
C’ GFP library in SD+DTT

cytosol549.161.16No -
C’ GFP library in SD+H2O2
cytosol447.990.95No -
C’ GFP library in Starvation Media

cytosol617.991.31No -
C’ GFP library on the background of Pup2-DaMP

punctate -
C’ GFP library on the background of CCT mutant

cytosol503.1041.07145No
